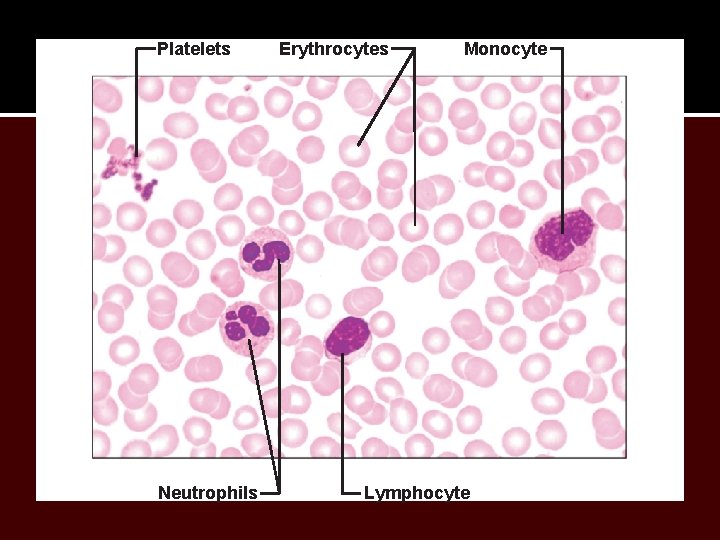
Platelets Neutrophils Erythrocytes Monocyte Lymphocyte

The Cardiovascular System Blood Platelets Neutrophils Erythrocytes Monocyte

The Cardiovascular System

Blood
Platelets Neutrophils Erythrocytes Monocyte Lymphocyte

2. 5 µm Side view (cut) 7. 5 µm Top view

Stem cell Hemocytoblast Committed cell Proerythroblast Developmental pathway Phase 1 Ribosome synthesis Phase 2 Hemoglobin accumulation Early Late erythroblast Phase 3 Ejection of nucleus Normoblast Reticulo- Erythrocyte

Differential WBC count (All total 4800 – 10, 800/l) Formed elements Platelets Leukocytes Granulocytes Neutrophils (50 – 70%) Eosinophils (2 – 4%) Basophils (0. 5 – 1%) Erythrocytes Agranulocytes Lymphocytes (25 – 45%) Monocytes (3 – 8%)

(a) Neutrophil; multilobed nucleus (b) Eosinophil; bilobed nucleus, red cytoplasmic granules (c) Basophil; bilobed nucleus, purplish-black cytoplasmic granules

(d) Small lymphocyte; large spherical nucleus (e) Monocyte; kidney-shaped nucleus


Platelets Stem cell Developmental pathway Hemocytoblast Promegakaryocyte Megakaryoblast Megakaryocyte Platelets

Step 1 Vascular spasm • Smooth muscle contracts, causing vasoconstriction. Collagen fibers Step 2 Platelet plug formation • Injury to lining of vessel exposes collagen fibers; platelets adhere. • Platelets release chemicals that make nearby platelets sticky; platelet plug forms. Platelets Fibrin Step 3 Coagulation • Fibrin forms a mesh that traps red blood cells and platelets, forming the clot.


The Heart

Superior vena cava Aorta Parietal pleura (cut) Pulmonary trunk Left lung Pericardium (cut) Diaphragm Apex of heart

Pulmonary trunk Pericardium Myocardium Fibrous pericardium Parietal layer Pericardial cavity Epicardium (visceral layer) Myocardium Endocardium Heart chamber

Brachiocephalic trunk Superior vena cava Right pulmonary artery Ascending aorta Pulmonary trunk Right pulmonary veins Right atrium Right coronary artery (in coronary sulcus) Anterior cardiac vein Right ventricle Right marginal artery Small cardiac vein Inferior vena cava Left common carotid artery Left subclavian artery Aortic arch Ligamentum arteriosum Left pulmonary artery Left pulmonary veins Auricle of left atrium Circumflex artery Left coronary artery (in coronary sulcus) Left ventricle Great cardiac vein Anterior interventricular artery (in anterior interventricular sulcus) Apex

Aorta Left pulmonary artery Left pulmonary veins Auricle of left atrium Left atrium Great cardiac vein Posterior vein of left ventricle Left ventricle Apex Superior vena cava Right pulmonary artery Right pulmonary veins Right atrium Inferior vena cava Coronary sinus Right coronary artery (in coronary sulcus) Posterior interventricular artery (in posterior interventricular sulcus) Middle cardiac vein Right ventricle

Aorta Superior vena cava Right pulmonary artery Pulmonary trunk Right atrium Right pulmonary veins Fossa ovalis Pectinate muscles Tricuspid valve Right ventricle Chordae tendineae Trabeculae carneae Inferior vena cava Left pulmonary artery Left atrium Left pulmonary veins Mitral (bicuspid) valve Aortic valve Pulmonary valve Left ventricle Papillary muscle Interventricular septum Epicardium Myocardium Endocardium

Pulmonary Circuit Pulmonary arteries Venae cavae Capillary beds of lungs where gas exchange occurs Pulmonary veins Aorta and branches Left atrium Left ventricle Right atrium Right ventricle Oxygen-rich, CO 2 -poor blood Oxygen-poor, CO 2 -rich blood Heart Systemic Circuit Capillary beds of all body tissues where gas exchange occurs

Superior vena cava Anastomosis (junction of vessels) Right atrium Aorta Pulmonary trunk Left atrium Left coronary artery Circumflex artery Right coronary Left artery ventricle Right ventricle Anterior Right interventricular marginal Posterior artery interventricular artery The major coronary arteries

Superior vena cava Anterior cardiac veins Great cardiac vein Coronary sinus Small cardiac vein Middle cardiac vein The major cardiac veins

QRS complex Sinoatrial node Atrial depolarization Ventricular repolarization Atrioventricular node P-Q Interval S-T Segment Q-T Interval

Blood Vessels and Circulation

Venous system Large veins (capacitance vessels) Arterial system Heart Large lymphatic vessels Lymph node Lymphatic system Small veins (capacitance vessels) Elastic arteries (conducting vessels) Muscular arteries (distributing vessels) Arteriovenous anastomosis Sinusoid Lymphatic capillary Arterioles (resistance vessels) Postcapillary venule Thoroughfare channel Terminal arteriole Metarteriole Precapillary sphincter Capillaries (exchange vessels)

Precapillary sphincters Vascular shunt Metarteriole Thoroughfare channel True capillaries Terminal arteriole Postcapillary venule (a) Sphincters open—blood flows through true capillaries. Terminal arteriole Postcapillary venule (b) Sphincters closed—blood flows through metarteriole thoroughfare channel and bypasses true capillaries.

Arteries of the head and trunk Internal carotid artery External carotid artery Common carotid arteries Vertebral artery Subclavian artery Brachiocephalic trunk Aortic arch Ascending aorta Coronary artery Thoracic aorta (above diaphragm) Arteries that supply the upper limb Subclavian artery Axillary artery Brachial artery Radial artery Ulnar artery Deep palmar arch Celiac trunk Superficial palmar arch Abdominal aorta Digital arteries Superior mesenteric artery Renal artery Gonadal artery Common iliac artery Inferior mesenteric artery Internal iliac artery Arteries that supply the lower limb External iliac artery Femoral artery Popliteal artery Anterior tibial artery Posterior tibial artery Arcuate artery

Ophthalmic artery Basilar artery Vertebral artery Internal carotid artery External carotid artery Common carotid artery Thyrocervical trunk Costocervical trunk Subclavian artery Axillary artery Branches of the external carotid artery • Superficial temporal artery • Maxillary artery • Occipital artery • Facial artery • Lingual artery • Superior thyroid artery Larynx Thyroid gland (overlying trachea) Clavicle (cut) Brachiocephalic trunk Internal thoracic artery Arteries of the head and neck, right aspect

Anterior Frontal lobe Optic chiasma Cerebral arterial circle (circle of Willis) • Anterior communicating artery • Anterior cerebral artery • Posterior communicating artery • Posterior cerebral artery Basilar artery Middle cerebral artery Internal carotid artery Mammillary body Temporal lobe Pons Occipital lobe Vertebral artery Cerebellum Posterior Major arteries serving the brain (inferior view, right side of cerebellum and part of right temporal lobe removed)

Vertebral artery Thyrocervical trunk Suprascapular artery Costocervical trunk Thoracoacromial artery Axillary artery Posterior circumflex humeral artery Anterior circumflex humeral artery Subscapular artery Brachial artery Deep artery of arm Common interosseous artery Common carotid arteries Left subclavian artery Right subclavian artery Brachiocephalic trunk Posterior intercostal arteries Anterior intercostal artery Internal thoracic artery Descending aorta Lateral thoracic artery Radial artery Ulnar artery Deep palmar arch Superficial palmar arch Digital arteries Illustration, anterior view

Veins of the head and trunk Dural venous sinuses External jugular vein Vertebral vein Internal jugular vein Right and left brachiocephalic veins Superior vena cava Great cardiac vein Hepatic veins Splenic vein Hepatic portal vein Renal vein Superior mesenteric vein Inferior vena cava Inferior mesenteric vein Veins that drain the upper limb Subclavian vein Axillary vein Cephalic vein Brachial vein Basilic vein Median cubital vein Ulnar vein Radial vein Digital veins Veins that drain the lower limb External iliac vein Femoral vein Great saphenous vein Common iliac vein Popliteal vein Internal iliac vein Posterior tibial vein Anterior tibial vein Illustration, anterior view. The vessels of the pulmonary circulation are not shown. Small saphenous vein Dorsal venous arch Dorsal metatarsal veins

Superficial temporal vein Occipital vein Posterior auricular vein External jugular vein Ophthalmic vein Facial vein Vertebral vein Internal jugular vein Superior and middle thyroid veins Brachiocephalic vein Subclavian vein Superior vena cava Veins of the head and neck, right superficial aspect

Brachiocephalic veins Right subclavian vein Axillary vein Brachial vein Cephalic vein Basilic vein Median cubital vein Median antebrachial vein Internal jugular vein External jugular vein Left subclavian vein Superior vena cava Azygos vein Accessory hemiazygos vein Hemiazygos vein Posterior intercostals Inferior vena cava Ascending lumbar vein Cephalic vein Basilic vein Radial vein Ulnar vein Deep palmar venous arch Superficial palmar venous arch Digital veins Anterior view

Inferior vena cava (not part of hepatic portal system) Hepatic veins Liver Hepatic portal vein Small intestine Rectum The hepatic portal circulation. Gastric veins Spleen Inferior vena cava Splenic vein Right gastroepiploic vein Inferior mesenteric vein Superior mesenteric vein Large intestine
- Slides: 33